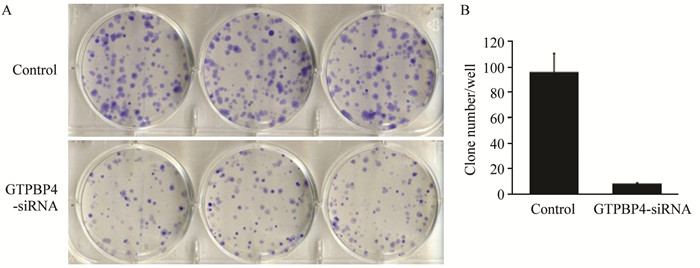

文章信息
- RNAi沉默GTPBP4基因对结肠癌RKO细胞增殖及凋亡的影响
- Effects of RNAi Silencing GTPBP4 Gene on Proliferation and Apoptosis of Colon Cancer RKO Cells
- 肿瘤防治研究, 2017, 44(1): 23-27
- Cancer Research on Prevention and Treatment, 2017, 44(1): 23-27
- http://www.zlfzyj.com/CN/10.3971/j.issn.1000-8578.2017.01.005
- 收稿日期: 2016-07-01
- 修回日期: 2016-10-27
结肠癌(colorectal cancer, CRC)是临床上最常见的一种消化道恶性肿瘤,全球每年约有120万新发病例,居全世界恶性肿瘤发病率的第四位[1]。到目前为止,结肠癌发病机制仍不十分清楚。人类GTP结合蛋白4(GTP binding protein4,GTPBP4)基因位于人染色体10p15-p14(基因库编号:DQ496111.1),是一条长12 285 bp的线性DNA序列[2]。GTPBP4基因在肿瘤的发生中可能起到重要作用。野生型P53乳腺癌患者个体中,GTPBP4蛋白表达水平升高者生存率降低[3]。也有报道指出GTPBP4基因与白血病的耐药性[4]及神经纤维瘤的发生有关[5]。本课题组前期研究(待发表)发现GTPBP4 mRNA在结直肠癌组织中的表达水平显著高于癌旁组织,并已成功构建GTPBP4 RNA干扰慢病毒载体GTPBP4-siRNA。本实验拟将GTPBP4-siRNA转染结肠癌RKO细胞,观察GTPBP4对RKO细胞增殖、凋亡等生物学行为的影响。
1 材料与方法 1.1 材料TRIzol(美国Invitrogen公司),M-MLV反转录酶、dNTPs、Rnase Inhibitor(均购自美国Promega公司),Oligo dT(上海生工公司),Primer(上海吉凯公司),pGCSIL-GFP慢病毒载体(上海吉凯公司),胎牛血清FBS、DMEM(美国Gibco公司),DMSO(上海生物试剂厂),胰酶(上海化学试剂公司),PI(美国Sigma P4170),Opti-MEM、RPMI1640(美国Invitrogen公司),双抗(上海双向西巴斯公司),MTT(北京鼎国生物技术有限责任公司),凋亡试剂盒(美国ebioscience 88-8007),Cellomics(美国Thermo公司),流式细胞仪(FACSCalibur,美国BD公司),酶标仪Biotek Elx800(美国BioTek公司)。
1.2 方法 1.2.1 慢病毒感染RKO细胞及GTPBP4敲减效率的检测取处于对数生长期的目的细胞,胰酶消化,制成细胞悬液;将细胞悬液(细胞数约为5×104个)接种于6孔板中,37℃、5%CO2培养箱中培养至细胞融合度达到约30%;根据细胞MOI值,加入适宜量GTPBP4-siRNA病毒,以CON053含非特异性干扰序列的阴性病毒为对照组。观察报告基因GFP的表达情况,荧光率大于80%者,同时取部分细胞提取RNA和蛋白,以Real-time PCR和Western blot检测敲减效率;感染效率低于80%的实验组,重新进行感染实验。
1.2.2 Cellomics细胞计数检测细胞生长将处于对数生长期的各实验组细胞胰酶消化,完全培养液重悬成细胞悬液;血球计数板对细胞进行计数;根据细胞生长快慢决定铺板细胞密度(多为2000个/室)。37℃、5%CO2培养,从铺板后第二天开始,每天Cellomics读板一次,连续3~5天。计算扫描孔板中的带绿色荧光的细胞数量并统计绘图,绘出5天的细胞增殖曲线。
1.2.3 AnnexinⅤ-APC单染法流式细胞仪检测细胞凋亡收集各实验组细胞于离心管,离心,弃上清液;PBS洗涤,再离心,收集细胞;1×binding buffer洗涤细胞沉淀一次,1500 r/min 5 min离心,收集细胞;1 ml 1×staining buffer重悬细胞沉淀;取细胞悬液100 μl(1×105~1×106个细胞),加入5 μl AnnexinⅤ-APC染色,室温避光10~15 min;转移至流式上机管中,上机检测。
1.2.4 FACS法进行细胞周期检测待各实验组细胞生长至覆盖率约为80%时,完全培养液终止培养,收集细胞,PBS洗涤,PI染色,FACS分析。
1.2.5 细胞克隆形成检测将处于对数生长期的各实验组细胞胰酶消化,制成细胞悬液,血球计数板对细胞悬液进行细胞计数。各实验组按800个/孔接种于6孔培养板中,每个实验组设3个复孔。将接种好的细胞继续培养到14天或绝大多数单个克隆中细胞数大于50时为止。每孔加入1 ml多聚甲醛,固定30~60 min,PBS洗涤1次。每孔加入洁净、无杂质Giemsa染液500 μl,染色20 min,ddH2O洗涤数次,拍照,计数。
1.2.6 MTT法检测细胞增殖按试剂盒说明书进行操作。
1.3 统计学方法采用SPSS16.0进行统计学分析。实时荧光定量PCR及蛋白质印迹法结果中各组计量资料数据用(x±s)表示,多组间均数的比较采用单因素方差分析(One-Way ANOVA);组内两两比较采用LSD方法。检验水准α=0.05。
2 结果 2.1 慢病毒成功感染RKO细胞根据细胞MOI值,用慢病毒GTPBP4-siRNA(实验组)和CON053(阴性对照组)感染RKO细胞,荧光镜观察绿色荧光,当感染效率 > 95%时,感染成功,进行后续实验,见图 1。

|
| 图 1 荧光倒置显微镜观察siRNA慢病毒感染后(96h) RKO细胞的白光和荧光表达(×100) Figure 1 The white light and fluorescent expression of RKO cells infected by siRNA lentiviral (96h) observed under fluorescence inverted microscope (×100) |
对照组GTPBP4 mRNA表达量2-ΔΔCt值为(1.002±0.086),实验组为(0.208±0.007)。实验组较对照组显著下降(P < 0.001)。从Western blot灰度结果分析显示,转染病毒后,实验组RKO细胞中GTPBP4蛋白表达量较对照组显著降低。GTPBP4基因沉默后,其蛋白敲减效率达到72.9%,见图 2。

|
| GTPBP4 protein was significantly decreased in experimental group compared with control group; experimental group: GTPBP4-siRNA group 图 2 Western blot检测转染病毒后实验组与对照组RKO细胞中GTPBP4蛋白表达 Figure 2 GTPBP4 protein in control group and the experimental group detected by Western blot |
经siRNA慢病毒感染后,增殖倍数均值和细胞计数均值均显示实验组RKO细胞的增殖速率受到显著抑制,见图 3。

|
| A: the cell proliferation of the control group and the experimental group were observed under the inverted microscope for 5 days; B: cell proliferation number curve of the control group and the experimental group; C: the control group and the experimental group cell proliferation rate curve. The cell proliferation rate of RKO in experimental group was significantly lower than that in control group 图 3 Cellomics细胞计数检测细胞生长结果图 Figure 3 Cell growth results detected by cellomics cell count |
siRNA慢病毒感染后,实验组RKO细胞MTT值比值(即增殖倍数)减小,见图 4。

|
| After siRNA lentiviral infection, the RKO cell MTT ratio of the experimental group was reduced 图 4 RKO细胞MTT实验结果分析 Figure 4 Analysis of the MTT experimental results of RKO cells |
siRNA慢病毒感染后,实验组细胞处于G0/G1期、G2/M期显著增多,S期明显减少,提示GTPBP4基因与RKO细胞增殖周期分布相关,见表 1。

|
siRNA慢病毒感染后,实验组RKO细胞凋亡峰值明显高于对照组,且峰值出现时间早于对照组,表明实验组RKO凋亡细胞增加,见图 5。

|
| A: control group and experimental group apoptosis peak, the apoptosis of RKO cells in the experimental group was significantly higher than that in the control group, and the peak time was earlier than that of the control group; B: the apoptosis rate of the experimental group and the control group statistical chart 图 5 Annexin V-APC单染法流式细胞仪检测细胞凋亡峰值图 Figure 5 The apoptotic peak figure of V-APC Annexin single staining flow cytometry detect |
siRNA慢病毒感染后,与对照组相比,实验组RKO细胞集落数目减少,提示GTPBP4基因与RKO细胞的克隆形成能力相关,见图 6。
|
| Compared with the control group, the colony number of RKO cells in the experimental group was significantly decreased, P=0.0075 图 6 RKO细胞克隆形成实验 Figure 6 Cloning formation experiment of RKO cells |
GTPBP4,又称为Nog1基因、NF2相关GTP结合蛋白基因(NF2-associated GTP binding protein, NGB)或慢性肾功能衰竭基因(chronic renal failure gene, CRFG)。人类GTPBP4基因与酵母Nog1基因具有同源性。GTPBP4基因编码蛋白为GTP结合蛋白,位于细胞核。Nog1具有重要的生物学功能,其在核糖体合成的后期阶段发挥重要作用,尤其是核糖体60S亚基的合成[6]。Nog1能调节秀丽隐杆线虫的生长、发育、寿命及脂肪代谢[7]。Nog1敲除后导致生育能力下降,生长迟缓,寿命延长且更多的脂肪储存[7]。
目前GTPBP4与肿瘤的相关性研究较少。有研究发现GTPBP4可抑制胶质瘤细胞生长和侵袭,其机制是GTPBP4与抑癌蛋白merlin结合,抑制cyclin D1表达,从而抑制细胞增殖[5]。在肺癌细胞株及原发肺癌中GTPBP4表达均下调,用TSA和5-Aza治疗后GTPBP4表达升高。将GTPBP4导入肺癌细胞株后,细胞生长、克隆形成、血管生成和裸鼠肿瘤形成均会受到抑制[8]。这两个研究结果提示GTPBP4是潜在的肿瘤抑制基因,在肺癌及胶质瘤的发生发展过程中起着重要作用。与前两项研究截然相反的是,有研究发现在结肠癌细胞株中,GTPBP4基因沉默后,细胞增殖显著抑制,停滞于S期。进一步研究发现GTPBP4能结合P53,抑制P53功能,当GTPBP4基因沉默后,P53表达水平和转录活性均显著升高,其下游靶基因p21、Hdm2和Puma mRNA表达水平也显著升高,GTPBP4是P53阴性调控子[3]。野生型P53乳腺癌患者个体中,GTPBP4蛋白表达水平升高者生存率降低[3]。这一研究结果提示,GTPBP4可能是促癌基因,且可能是通过抑制P53信号途径达到抑制肿瘤细胞增殖的作用。P53为重要的肿瘤抑制基因,与许多肿瘤的发生均有密切的关系。有研究发现,核糖体合成障碍会引起细胞应激反应,通过核糖体-Mdm2-p53(ribosomal protein-Mdm2-p53, RP-Mdm2-p53)途径阻碍MDM2与P53结合,致使P53泛素化降解障碍,P53活化,细胞周期停滞、细胞凋亡、自噬,在肿瘤发生过程中有重要作用[9-11]。本实验结果显示siRNA慢病毒感染后,成功敲减GTPBP4基因表达。RKO细胞株GTPBP4基因表达抑制后,细胞的增殖速率也受到显著抑制;处于G0/G1、G2/M期细胞显著增多,S期明显减少。在GTPBP4基因抑制后,处于S期RKO细胞减少,与文献报道结果一致[3]。根据文献报道及本研究结果提示,GTPBP4可能是促癌基因,且可能是通过调节P53信号途径来调节细胞周期,从而促进肿瘤细胞增殖、抑制凋亡而影响结肠癌的发生发展。因为GTPBP4在核糖体合成中具有重要作用,故推测GTPBP4可能通过RP-Mdm2-p53信号途径致肿瘤发生,但该假设还需要进一步研究。
该研究初步探讨了GTPBP4基因在结肠癌发生发展中的作用,虽然其发病机制还不是很明确,但该结果为GTPBP4在结肠癌发生发展中的作用研究奠定了基础,提供了假设,为探索GTPBP4在肿瘤治疗新方法提供了新思路。
| [1] | Boyle P, Langman JS. ABC of colorectal cancer: Epidemiology[J]. BMJ, 2000, 321 (7264) : 805–8. DOI:10.1136/bmj.321.7264.805 |
| [2] | Currie D, McKnight AJ, Patterson CC, et al. Association of microsatellite markers on chromosomes 6q27 region and 10p15 region with end-stage renal disease in a UK renal transplant population[J]. J Human Genet, 2009, 54 (8) : 497–8. DOI:10.1038/jhg.2009.53 |
| [3] | Lunardi A, Di Minin G, Provero P, et al. A genome-scale protein interaction profile of Drosophila p53 uncovers additional nodes of the human p53 network[J]. Proc Natl Acad Sci U S A, 2010, 107 (14) : 6322–7. DOI:10.1073/pnas.1002447107 |
| [4] | Chouchana L, Fernández-Ramos AA, Dumont F, et al. Molecular insight into thiopurine resistance:transcriptomic signature in lymphoblastoid cell lines[J]. Genome Med, 2015, 7 (1) : 37. DOI:10.1186/s13073-015-0150-6 |
| [5] | Lee H, Kim D, Dan HC, et al. Identification and Characterization of Putative Tumor Suppressor NGB, a GTP-Binding Protein That Interacts with the Neurofibromatosis 2 Protein[J]. Mol Cell Biol, 2007, 27 (6) : 2103–19. DOI:10.1128/MCB.00572-06 |
| [6] | Jensen BC, Wang Q, Kifer CT, et al. The NOG1 GTP-binding protein is required for biogenesis of the 60 S ribosomal subunit[J]. J Biol Chem, 2003, 278 (34) : 32204–11. DOI:10.1074/jbc.M304198200 |
| [7] | Kim YI, Bandyopadhyay J, Cho I, et al. Nucleolar GTPase NOG-1 regulates development, fat storage, and longevity through insulin/IGF signaling in C. elegans[J]. Mol Cells, 2014, 37 (1) : 51–7. DOI:10.14348/molcells.2014.2251 |
| [8] | Kim D, Park S, Sang HL, et al. Frequent downregulation of NGB/GTPBP in lung cancer[J]. Cancer Res, 2012, 72 (8) : 3139. |
| [9] | Stępiński D. Nucleolus-derived mediators in oncogenic stress response and activation of p53-dependent pathways[J]. Histochem Cell Biol, 2016, 146 (2) : 119–39. DOI:10.1007/s00418-016-1443-6 |
| [10] | Sagar V, Caldarola S, Aria V, et al. PIM1 destabilization activates a p53-dependent response to ribosomal stress in cancer cells[J]. Oncotarget, 2016, 7 (17) : 23837–49. |
| [11] | Scala F, Brighenti E, Govoni M, et al. Direct relationship between the level of p53 stabilization induced by rRNA synthesis-inhibiting drugs and the cell ribosome biogenesis rate[J]. Oncogene, 2016, 35 (8) : 977–89. DOI:10.1038/onc.2015.147 |
 2017, Vol. 44
2017, Vol. 44


